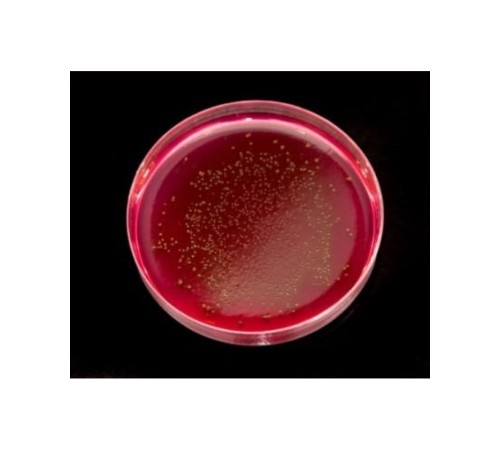
Купить Питательный бульон 100 г.

Не является лекарственным (фармацевтическим) препаратом. Не является БАД.
Не предназначен для проведения любых медицинских исследований или процедур.
Продажу химических реактивов осуществляем только юридическим лицам.
Предназначен для культивирования широкого спектра микроорганизмов, для накопления и изучения свойств бактериальных культур при санитарных исследованиях пищевых продуктов и объектов внешней среды.
Среда является аналогом мясо-пептонного бульона или бульона Хоттингера.
Сухая питательная среда по ТУ 10-02-02-789-176-94)
Фасовка в пластиковые банки по 100 г.
Расход среды 30г/дм3.
Срок годности – 2 года.
Цена дана за 1 упаковку с учетом НДС 20 %.
Нет отзывов об этом товаре.
Нет вопросов об этом товаре.
Доставка заказов осуществляется в любые регионы Российской Федерации и страны СНГ.
Цены на нашем сайте указаны с учетом НДС (20% либо 10%).
Оплата заказов производится только в безналичной форме на расчетный счет в рублях Российской Федерации на основании выставленного Счета.
Для бюджетных организаций и государственных структур предусмотрены особые условия оплаты.
Постоянным клиентам предоставляются скидки и индивидуальный порядок расчетов.
Внимание! В связи с нестабильным курсом валют и изменением цен у производителей, просим окончательную стоимость продукции уточнять у наших менеджеров.
Варианты доставки:
Самовывоз со склада в городе Клин
Адрес выдачи: Московская область, г. Клин, ул. Захватаева, д. 4, офис 101
Контактный телефон: +7 (977) 407-05-96
Доставка по Клину и Клинскому району – бесплатно
Доставка по Москве – 1 500 рублей
Доставка любыми транспортными компаниями, службами экспресс-доставки. Стоимость рассчитывается индивидуально для каждого заказа в соответствии с установленными тарифами транспортной компании. Все грузы застрахованы.
Компания "КомплектСнаб является официальным поставщиком от производителя НПЦ «Биокомпас-С». Вы всегда можете получить бесплатную консультацию по продукции, получить КП и задать вопросы по подбору аналогов продукции.








